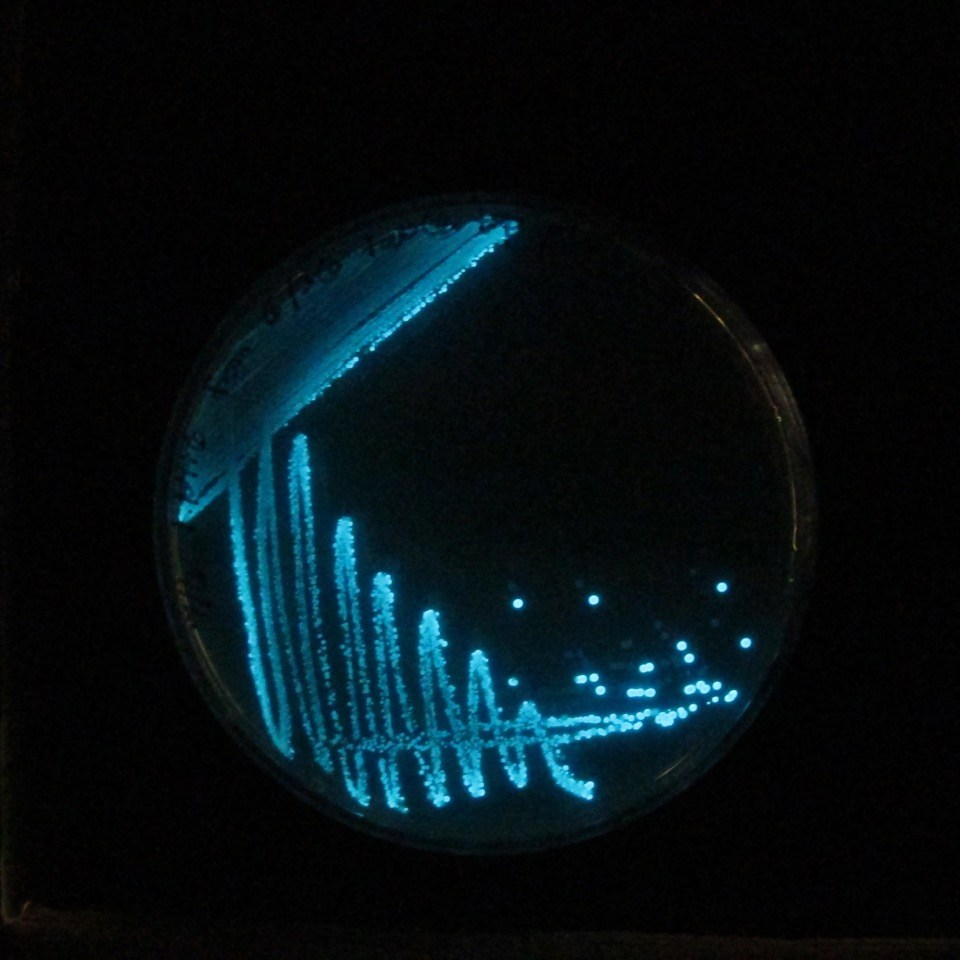

Did the title make you look?
WordPress would have me believe that a compelling title is all I need to make it in the blog-o-sphere. So let’s test that hypothesis.
What were you thinking when you read the title? Petri dishes and inoculating loops? Lights across the sky? Naked runners? Hair highlights? DuoLingo?

Honestly, it’s Thursday and I am dead tired from another week of emergency remote teaching. I was contemplating just packing it in and hitting the hay early. But then I would lose my 24 day streak of consecutive blog posts.
Why is it that motivational nudges and earning badges work? Our Apple watches tells us that we can still close our rings. “A brisk 10 minute walk should do it.” Facebook assigns “Top Contributor”, “Rising Star”, and “Founding Member” badges for group participants. DuoLingo keeps us working to maintain our daily streak. And WordPress urges me to sustain my posting streak. Gosh darn it, it works…at least on me.
Maybe this need to achieve can be used to help our students succeed.
So here is my gratuitous post to maintain my streak. Hopefully the title is intriguing, the pictures amusing, and the words interesting enough that you will return in the future.
One thought on “May 14 Day 67: Streaking”